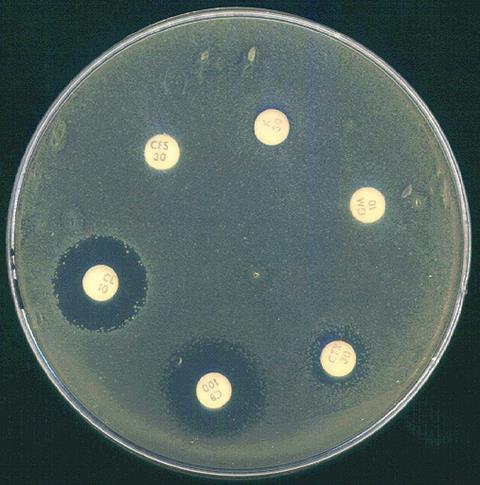
Ab_Acinetobacter_B_1

Over the decades, many strains of disease-causing bacteria have evolved defenses to even the most potent antibiotics, setting off a growing health crisis. The rise of antibiotic-resistant superbugs has also set off an arms race. As pathogens find new ways to withstand drugs, researchers are looking for new ways to break down their defenses.
In a significant step forward, a research team led by Yan Yu, the Art Krieg Professor of Chemistry, in Arts & Sciences, and of biomedical engineering, at the McKelvey School of Engineering, has restored the power of failing antibiotics by combining them with two-sided nanoparticles, ultra-small building blocks of materials less than 100 nanometers across. The nanoparticles showed a remarkable ability to compromise bacterial cell walls, leaving the germs vulnerable to attack.
“The nanoparticles supercharged the antibiotics,” Yu said. “This research could point to a new way to give new life to old anti-bacterial drugs.”
The study was reported in Nano Letters, a journal of the American Chemical Society. It was co-authored by Yu’s colleagues at Indiana University and Osaka University in Japan.
Inspired by Roman god
Yu and the team created nanoparticles with two distinct sides. Called Janus nanoparticles after the two-faced Roman god of beginnings and endings, the particles double the possibilities for chemists. One face was coated in positively charged molecules that help the nanoparticle attach to the bacterial cell wall. The other face is coated with hydrophobic (water-repelling) molecules that cause the cell wall to rupture. “A single Janus nanoparticle carries two punches in one shot,” Yu said.
Once the cell wall is compromised, antibiotics have a much easier time infiltrating and eventually killing germs, Yu explained. The team found that the combination of Janus nanoparticles and antibiotics killed colonies of drug-resistant strains of E. coli and A. baumannii — two types of bacteria that pose a significant human health risk — more efficiently than antibiotics alone. One of the strains of A. baumannii was an antibiotic-resistant variety collected from a hospital.
READ MORE: Pathogens use force to breach immune defenses, study finds
Other types of nanoparticles have been used to fight bacteria, and, in some cases, the germs have shown an ability to evolve defenses against the small-scale threats, Yu explained. But because Janus nanoparticles take a two-pronged attack directly to the cell wall, evolving any sort of resistance would likely be a slow, complicated process, she said. “If bacteria do develop some sort of resistance, it will likely be over a long time scale.”
Tunable nanoparticles
In the event that bacteria built up defenses to one particular type of two-faced nanoparticle, researchers could always tweak the molecules attached to each side. “Janus nanoparticles are tunable and adjustable, which is a huge advantage,” Yu said.
In the future, Yu hopes to start new collaborations with researchers across WashU, including those at the McKelvey School of Engineering and at WashU Medicine. She would like to work with clinicians to test Janus nanoparticles in hospital settings, perhaps including wound healing in patients. She also would like to collaborate with researchers in chemistry and in engineering to explore new options for customizing the nanoparticles and manufacturing them in large quantities for clinical applications.
No comments yet